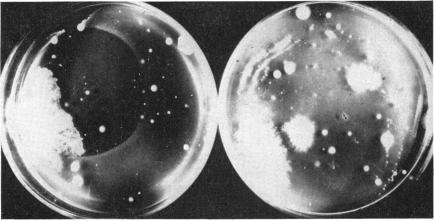
https://cdn.ncbi.nlm.nih.gov/pmc/blobs/8c66/518561/5fbbc060a278/jbacter00648-0035-a.jpg

A Method for Investigating Large Microbial Populations for Antibiotic Activity.
作者信息
Kelner A
机构信息
Laboratories of the Medical School, University of Pennsylvania, Philadelphia, Pennsylvania.
出版信息
J Bacteriol. 1948 Aug;56(2):157-62. doi: 10.1128/jb.56.2.157-162.1948.
Abstract
摘要